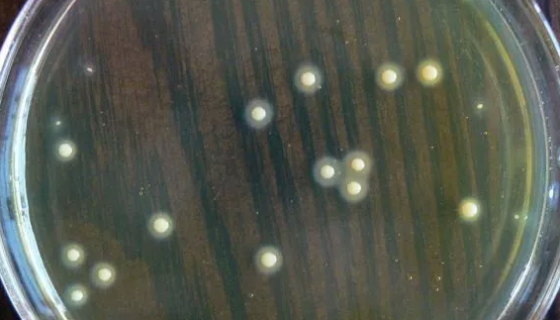
白色葡萄球菌的培养与灭菌方法及主要用途！
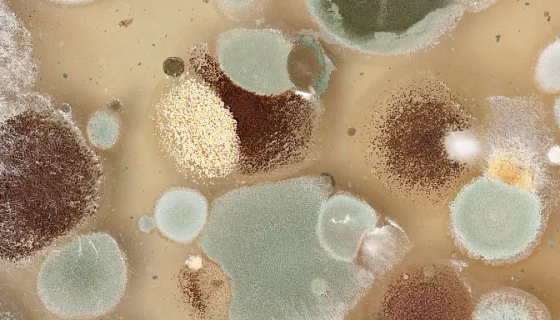
匍匐放射毛霉或雅致放线毛霉单层冻干管打管说明！

SCC-15人舌磷癌细胞的培养与使用操作步骤!
人舌鳞癌细胞源自属于I级鳞癌(T2N1Amo,Ⅱ期)的原位舌...

吸水链霉菌吸水亚种的培养方法与实验内容!
吸水链霉菌吸水亚种是Streptomyces属的微生物,原产...

RTG鲑鱼胚胎细胞的处理方法与培养步骤!
鲑鱼胚胎细胞分离自脑组织;大脑分左右两个半球,大脑皮质(灰质...

ATCC 19423 溃疡分枝杆菌 百欧博伟生物
溃疡分枝杆菌,中等长杆菌。在蛋培养基上30—33℃培育4周后...

乳酸片球菌的功效用途与使用方法及操作步骤!
乳酸片球菌,拉丁名:Pediococcusacidilact...

NPC/HK-1人鼻咽癌细胞的培养方法与注意事项!
人鼻咽癌细胞仅用于科学研究或者工业应用等非医疗目的不可用于人...
白色葡萄球菌的培养与灭菌方法及主要用途!
白色葡萄球菌系葡萄球菌的一种,除具有一般葡萄球菌特性外,还能...
匍匐放射毛霉或雅致放线毛霉单层冻干管打管说明!
匍匐放射毛霉或雅致放线毛霉的知识简介与注意事项及打管说明。

人非小细胞肺癌细胞的处理方法与培养步骤!
人非小细胞肺癌细胞,仅用于科学研究或者工业应用等非医疗目的不...